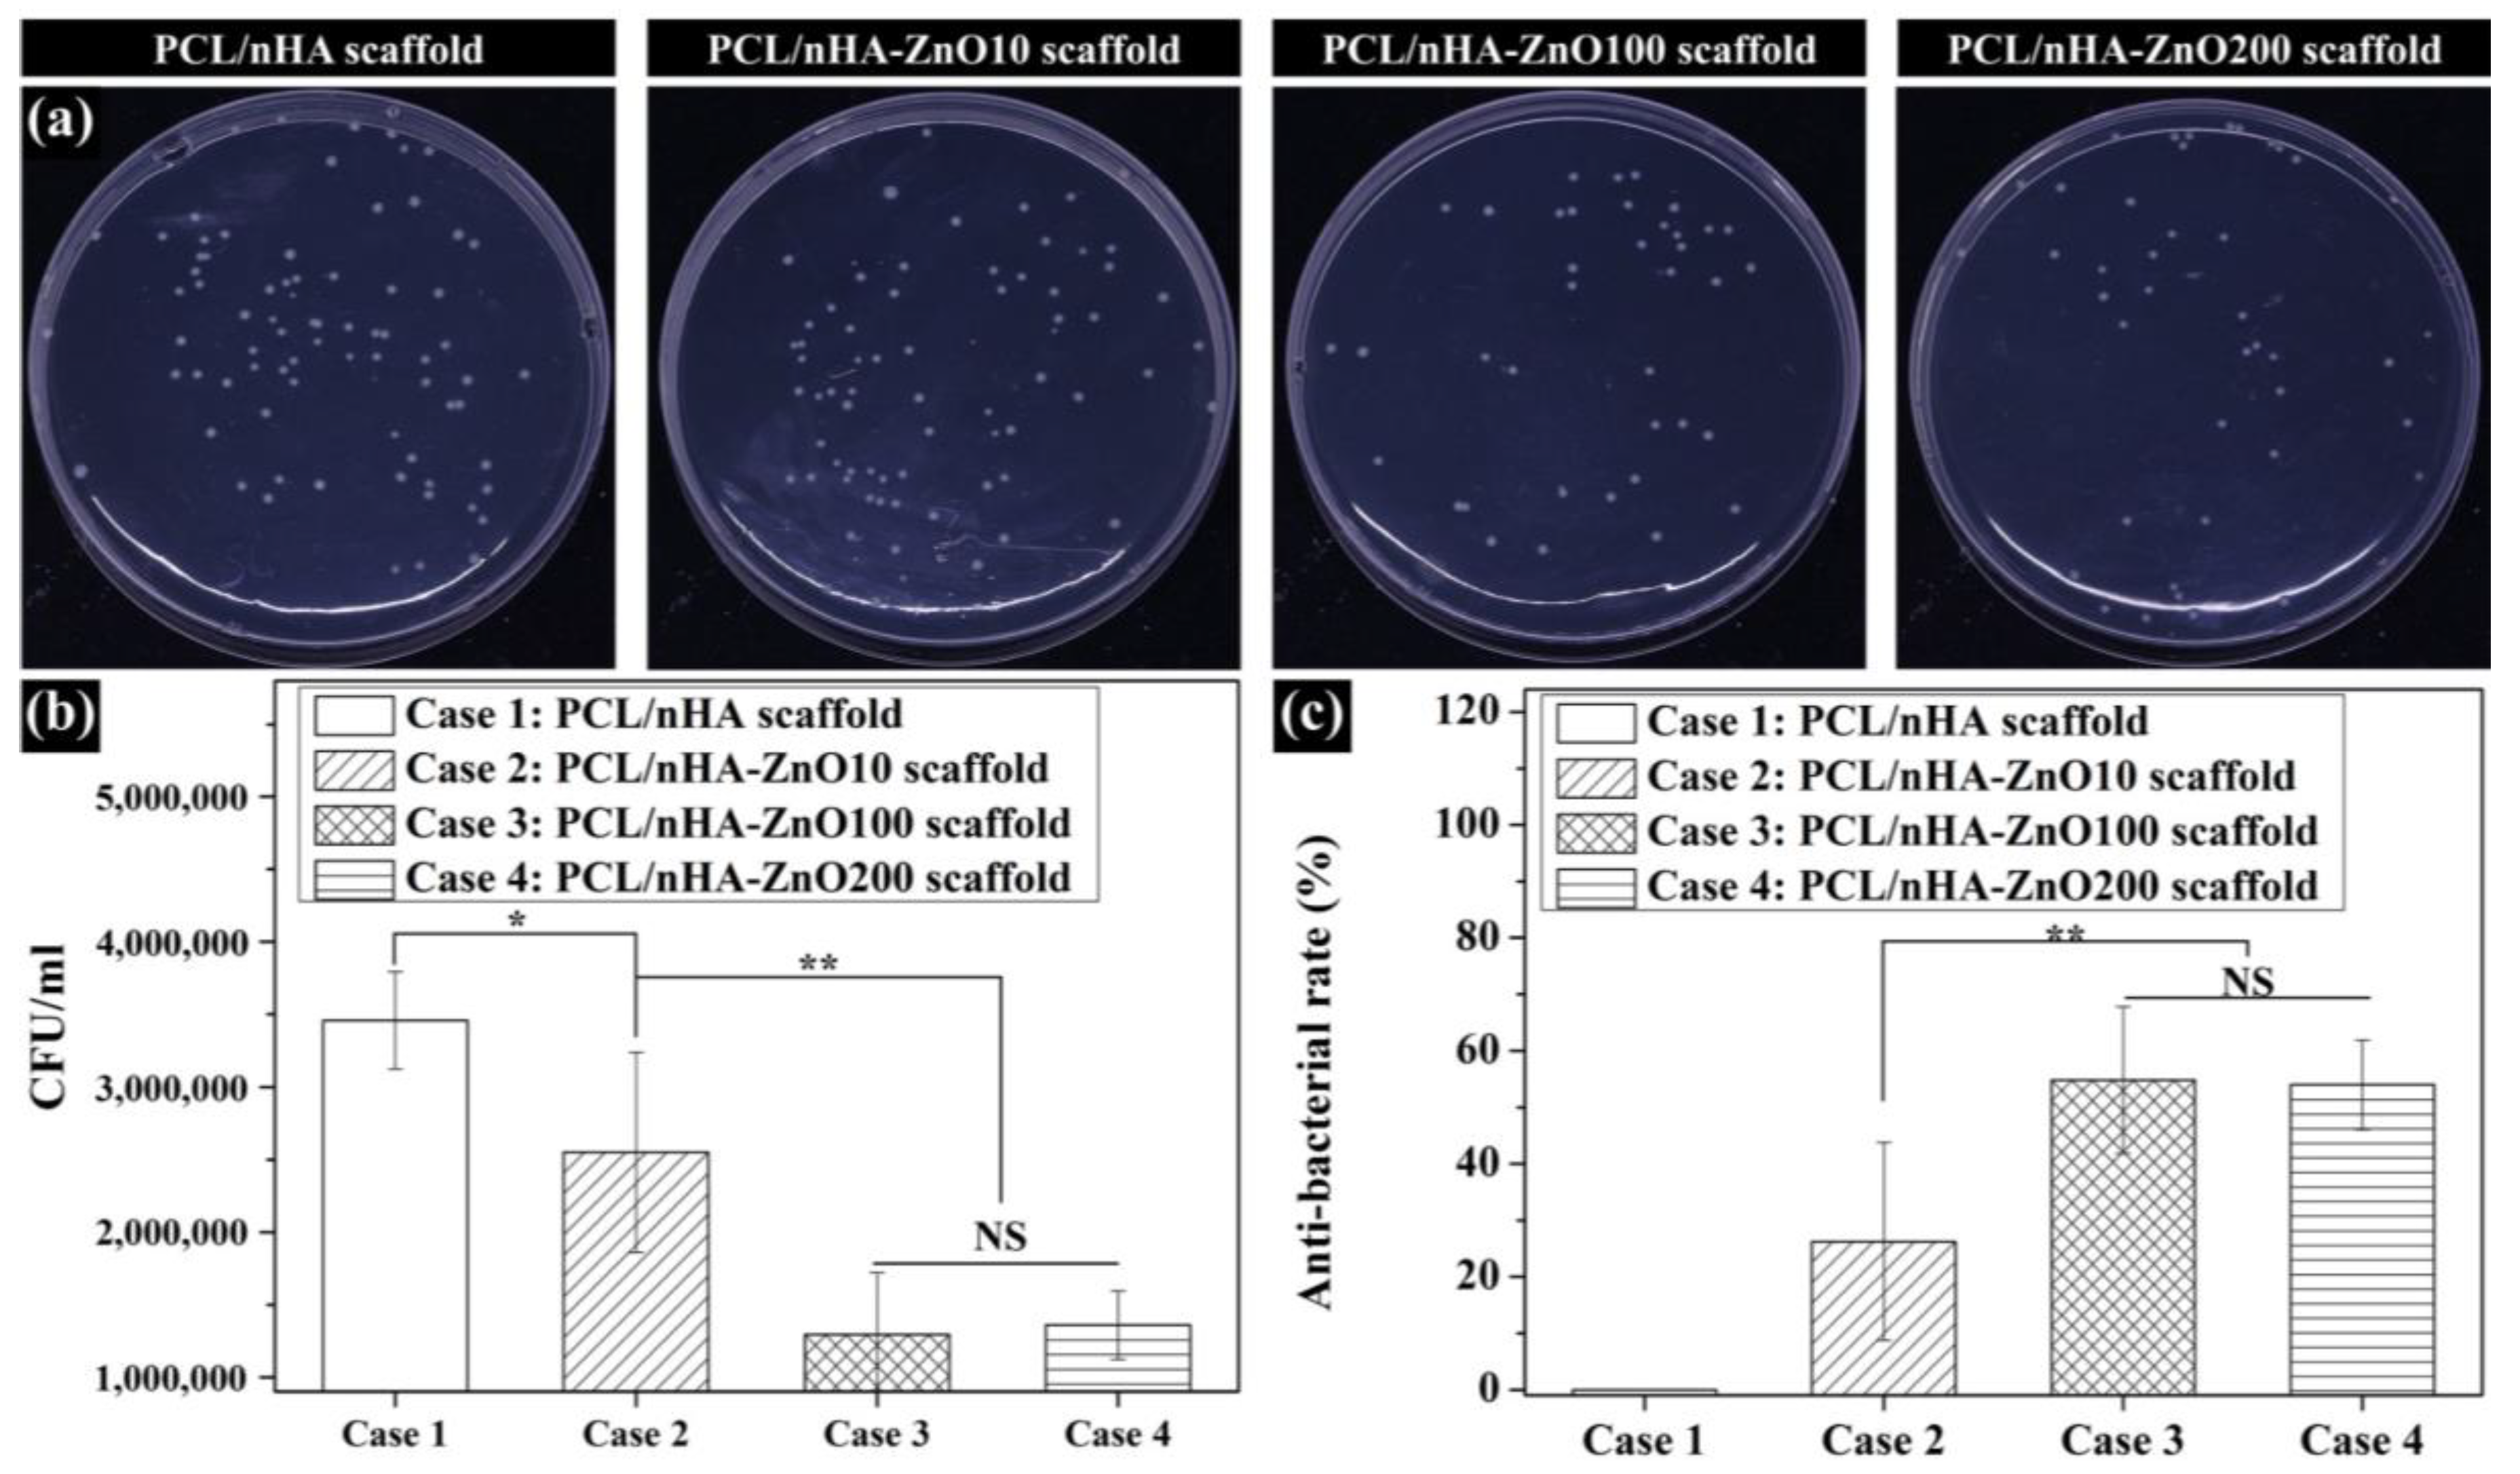
Polymers 12 02193 g007

Evaluation of the Antibacterial Activity and Cell Response for 3D-Printed Polycaprolactone/Nanohydroxyapatite Scaffold with Zinc Oxide Coating
Abstract
:1. Introduction
2. Materials and Methods
2.1. Design of PCL/nHA Scaffold with a Periodic Kagome Structure
2.2. Preparation and Fabrication of PCL/nHA Scaffold with Kagome Structure and Zinc Oxide Coating
2.3. Analysis of the Characteristics of Fabricated Scaffolds
2.4. Measuring Water Absorption Ability and the Concentration of Zinc Ions Released from the Scaffolds
2.5. Assessment of In Vitro Antibacterial Activity of PCL/nHA-Zinc Oxide Scaffold
2.6. Assessment of In Vitro Cell Viability and Growth on PCL/nHA-Zinc Oxide Scaffold
2.7. Statistical Analysis
3. Results
3.1. Investigation of the Scaffold’s Characteristics According to the Zinc Oxide Coating Thickness
3.2. Evaluation of the Scaffold’s Molecular Weight, Water Absorption, and Concentration of Zinc Ions Released
3.3. Evaluation of the Antibacterial Activity of Zinc Oxide Coating on the Fabricated Scaffolds
3.4. In Vitro Cell Viability and Proliferation on the Fabricated Scaffolds
4. Discussion
5. Conclusions
Supplementary Materials
Author Contributions
Funding
Conflicts of Interest
References
- Moreau-Marquis, S.; Stanton, B.A.; O’Toole, G.A. Pseudomonas aeruginosa biofilm formation in the cystic fibrosis airway. Pulm. Pharmacol. Ther. 2008, 21, 595–599. [Google Scholar] [CrossRef] [Green Version]
- Han, S.; Ji, S.; Abdullah, A.; Kim, D.; Lim, H.; Lee, D. Superhydrophilic nanopillar-structured quartz surfaces for the prevention of biofilm formation in optical devices. Appl. Surf. Sci. 2018, 429, 244–252. [Google Scholar] [CrossRef]
- Al-Mulhim, F.A.; Baragbah, M.A.; Sadat-Ali, M.; Alomran, A.S.; Azam, M.Q. Prevalence of surgical site infection in orthopedic surgery: A 5-year analysis. Int. Surg. 2014, 99, 264–268. [Google Scholar] [CrossRef] [PubMed] [Green Version]
- Tripathy, A.; Sen, P.; Su, B.; Briscoe, W.H. Natural and bioinspired nanostructured bactericidal surfaces. Adv. Colloid Interface Sci. 2017, 248, 85–104. [Google Scholar] [CrossRef] [PubMed]
- Ivanova, E.P.; Hasan, J.; Webb, H.K.; Truong, V.K.; Watson, G.S.; Watson, J.A.; Baulin, V.A.; Pogodin, S.; Wang, J.Y.; Tobin, M.J.; et al. Natural bactericidal surfaces: Mechanical rupture of pseudomonas aeruginosa cells by cicada wings. Small 2012, 8, 2489–2494. [Google Scholar] [CrossRef] [PubMed]
- Bandara, C.D.; Singh, S.; Afara, I.O.; Wolff, A.; Tesfamichael, T.; Ostrikov, K.; Oloyede, A. Bactericidal Effects of Natural Nanotopography of Dragonfly Wing on Escherichia coli. ACS Appl. Mater. Interfaces 2017, 9, 6746–6760. [Google Scholar] [CrossRef] [Green Version]
- Kapat, K.; Maity, P.P.; Rameshbabu, A.P.; Srivas, P.K.; Majumdar, P.; Dhara, S. Simultaneous hydrothermal bioactivation with nano-topographic modulation of porous titanium alloys towards enhanced osteogenic and antimicrobial responses. J. Mater. Chem. B 2018, 6, 2877–2893. [Google Scholar] [CrossRef]
- Chen, W.; Long, T.; Guo, Y.J.; Zhu, Z.A.; Guo, Y.P. Hydrothermal synthesis of hydroxyapatite coatings with oriented nanorod arrays. RSC Adv. 2014, 4, 185–191. [Google Scholar] [CrossRef]
- Huang, Y.; Yan, Y.; Pang, X.; Ding, Q.; Han, S. Bioactivity and corrosion properties of gelatin-containing and strontium-doped calcium phosphate composite coating. Appl. Surf. Sci. 2013, 282, 583–589. [Google Scholar] [CrossRef]
- Diu, T.; Faruqui, N.; Sjöström, T.; Lamarre, B.; Jenkinson, H.F.; Su, B.; Ryadnov, M.G. Cicada-inspired cell-instructive nanopatterned arrays. Sci. Rep. 2014, 4, 7122. [Google Scholar] [CrossRef] [Green Version]
- Saxena, V.; Hasan, A.; Pandey, L.M. Effect of Zn/ZnO integration with hydroxyapatite: A review. Mater. Technol. 2018, 33, 79–92. [Google Scholar] [CrossRef]
- Qi, R.; Guo, R.; Zheng, F.; Liu, H.; Yu, J.; Shi, X. Controlled release and antibacterial activity of antibiotic-loaded electrospun halloysite/poly(lactic-co-glycolic acid) composite nanofibers. Colloids Surf. B Biointerfaces 2013, 110, 148–155. [Google Scholar] [CrossRef] [PubMed]
- Xu, Z.L.; Lei, Y.; Yin, W.J.; Chen, Y.X.; Ke, Q.F.; Guo, Y.P.; Zhang, C.Q. Enhanced antibacterial activity and osteoinductivity of Ag-loaded strontium hydroxyapatite/chitosan porous scaffolds for bone tissue engineering. J. Mater. Chem. B 2016, 4, 7919–7928. [Google Scholar] [CrossRef] [PubMed]
- Shi, Y.; Li, Y.; Zhang, J.; Yu, Z.; Yang, D. Electrospun polyacrylonitrile nanofibers loaded with silver nanoparticles by silver mirror reaction. Mater. Sci. Eng. C 2015, 51, 346–355. [Google Scholar] [CrossRef]
- Carvalho, P.; Sampaio, P.; Azevedo, S.; Vaz, C.; Espinós, J.P.; Teixeira, V.; Carneiro, J.O. Influence of thickness and coatings morphology in the antimicrobial performance of zinc oxide coatings. Appl. Surf. Sci. 2014, 307, 548–557. [Google Scholar] [CrossRef] [Green Version]
- Zhang, Y.; Chang, M.; Bao, F.; Xing, M.; Wang, E.; Xu, Q.; Huan, Z.; Guo, F.; Chang, J. Multifunctional Zn doped hollow mesoporous silica/polycaprolactone electrospun membranes with enhanced hair follicle regeneration and antibacterial activity for wound healing. Nanoscale 2019, 11, 6315–6333. [Google Scholar] [CrossRef]
- Tian, B.; Chen, W.; Dong, Y.; Marymont, J.V.; Lei, Y.; Ke, Q.; Guo, Y.; Zhu, Z. Silver nanoparticle-loaded hydroxyapatite coating: Structure, antibacterial properties, and capacity for osteogenic induction in vitro. RSC Adv. 2016, 6, 8549–8562. [Google Scholar] [CrossRef]
- Lemire, J.A.; Harrison, J.J.; Turner, R.J. Antimicrobial activity of metals: Mechanisms, molecular targets and applications. Nat. Rev. Microbiol. 2013, 11, 371–384. [Google Scholar] [CrossRef]
- Thian, E.S.; Konishi, T.; Kawanobe, Y.; Lim, P.N.; Choong, C.; Ho, B.; Aizawa, M. Zinc-substituted hydroxyapatite: A biomaterial with enhanced bioactivity and antibacterial properties. J. Mater. Sci. Mater. Med. 2013, 24, 437–445. [Google Scholar] [CrossRef]
- Thongsuriwong, K.; Amornpitoksuk, P.; Suwanboon, S. Structure, morphology, photocatalytic and antibacterial activities of ZnO thin films prepared by sol-gel dip-coating method. Adv. Powder Technol. 2013, 24, 275–280. [Google Scholar] [CrossRef]
- Voicu, G.; Miu, D.; Ghitulica, C.D.; Jinga, S.I.; Nicoara, A.I.; Busuioc, C.; Holban, A.M. Co doped ZnO thin films deposited by spin coating as antibacterial coating for metallic implants. Ceram. Int. 2020, 46, 3904–3911. [Google Scholar] [CrossRef]
- Chhabra, H.; Deshpande, R.; Kanitkar, M.; Jaiswal, A.; Kale, V.P.; Bellare, J.R. A nano zinc oxide doped electrospun scaffold improves wound healing in a rodent model. RSC Adv. 2016, 6, 1428–1439. [Google Scholar] [CrossRef]
- Francq, R.; Snyders, R.; Cormier, P.A. Structural and Morphological study of ZnO-Ag thin films synthesized by reactive magnetron co-sputtering. Vacuum 2017, 137, 1–7. [Google Scholar] [CrossRef]
- Liu, Y.; He, L.; Mustapha, A.; Li, H.; Hu, Z.Q.; Lin, M. Antibacterial activities of zinc oxide nanoparticles against Escherichia coli O157:H7. J. Appl. Microbiol. 2009, 107, 1193–1201. [Google Scholar] [CrossRef] [PubMed]
- Armentano, I.; Dottori, M.; Fortunati, E.; Mattioli, S.; Kenny, J.M. Biodegradable polymer matrix nanocomposites for tissue engineering: A review. Polym. Degrad. Stab. 2010, 95, 2126–2146. [Google Scholar] [CrossRef]
- Collins, M.N.; Birkinshaw, C. Hyaluronic acid based scaffolds for tissue engineering—A review. Carbohydr. Polym. 2013, 92, 1262–1279. [Google Scholar] [CrossRef] [PubMed]
- Motamedian, S.R. Smart scaffolds in bone tissue engineering: A systematic review of literature. World J. Stem Cells. 2015, 7, 657–668. [Google Scholar] [CrossRef]
- Tran, T.T.; Hamid, Z.A.; Cheong, K.Y. A Review of Mechanical Properties of Scaffold in Tissue Engineering: Aloe Vera Composites. J. Phys. Conf. Ser. 2018, 1082, 012080. [Google Scholar] [CrossRef]
- Cho, Y.S.; Quan, M.; Lee, S.-H.; Hong, M.W.; Kim, Y.Y.; Cho, Y.-S. Assessment of osteogenesis for 3D-printed polycaprolactone/hydroxyapatite composite scaffold with enhanced exposure of hydroxyapatite using rat calvarial defect model. Compos. Sci. Technol. 2019, 184, 107844. [Google Scholar] [CrossRef]
- Lee, S.-H.; Cho, Y.S.; Hong, M.W.; Lee, B.-K.; Park, Y.; Park, S.-H.; Kim, Y.Y.; Cho, Y.-S. Mechanical properties and cell-culture characteristics of a polycaprolactone kagome-structure scaffold fabricated by a precision extruding deposition system. Biomed. Mater. 2017, 12, 055003. [Google Scholar] [CrossRef]
- Cho, Y.S.; Quan, M.; Kang, N.U.; Jeong, H.J.; Hong, M.W.; Kim, Y.Y.; Cho, Y.-S. Strategy for enhancing mechanical properties and bone regeneration of 3D polycaprolactone kagome scaffold: Nano hydroxyapatite composite and its exposure. Eur. Polym. 2020, 134, 109814. [Google Scholar] [CrossRef]
- Chai, H.; Guo, L.; Wang, X.; Fu, Y.; Guan, J.; Tan, L.; Ren, L.; Yang, K. Antibacterial effect of 317L stainless steel contained copper in prevention of implant-related infection in vitro and in vivo. J. Mater. Sci. Mater. Med. 2011, 22, 2525–2535. [Google Scholar] [CrossRef] [PubMed]
- Akhi, M.T.; Ghotaslou, R.; Beheshtirouy, S.; Asgharzadeh, M.; Pirzadeh, T.; Asghari, B.; Alizadeh, N.; Toloue Ostadgavahi, A.; Sorayaei Somesaraei, V.; Memar, M.Y. Antibiotic Susceptibility Pattern of Aerobic and Anaerobic Bacteria Isolated from Surgical Site Infection of Hospitalized Patients. Jundishapur J. Microbiol. 2015, 8, e20309. [Google Scholar] [CrossRef] [Green Version]
- Mantila Roosa, S.M.; Kemppainen, J.M.; Moffitt, E.N.; Krebsbach, P.H.; Hollister, S.J. The pore size of polycaprolactone scaffolds has limited influence on bone regeneration in an in vivo model. J. Biomed. Mater. Res. Part. A 2010, 92, 359–368. [Google Scholar] [CrossRef]
- Sobral, J.M.; Caridade, S.G.; Sousa, R.A.; Mano, J.F.; Reis, R.L. Three-dimensional plotted scaffolds with controlled pore size gradients: Effect of scaffold geometry on mechanical performance and cell seeding efficiency. Acta Biomater. 2011, 7, 1009–1018. [Google Scholar] [CrossRef] [Green Version]
- Loh, Q.L.; Choong, C. Three-dimensional scaffolds for tissue engineering applications: Role of porosity and pore size. Tissue Eng. Part. B Rev. 2013, 19, 485–502. [Google Scholar] [CrossRef] [Green Version]
- Wang, M.O.; Vorwald, C.E.; Dreher, M.L.; Mott, E.J.; Cheng, M.H.; Cinar, A.; Mehdizadeh, H.; Somo, S.; Dean, D.; Brey, E.M.; et al. Evaluating 3D-printed biomaterials as scaffolds for vascularized bone tissue engineering. Adv. Mater. 2014, 27, 138–144. [Google Scholar] [CrossRef] [PubMed] [Green Version]
- Ning, C.; Wang, X.; Li, L.; Zhu, Y.; Li, M.; Yu, P.; Zhou, L.; Zhou, Z.; Chen, J.; Tan, G.; et al. Concentration Ranges of Antibacterial Cations for Showing the Highest Antibacterial Efficacy but the Least Cytotoxicity against Mammalian Cells: Implications for a New Antibacterial Mechanism. Chem. Res. Toxicol. 2015, 28, 1815–1822. [Google Scholar] [CrossRef] [Green Version]
- Kubásek, J.; Vojtěch, D.; Jablonská, E.; Pospíšilová, I.; Lipov, J.; Ruml, T. Structure, mechanical characteristics and in vitro degradation, cytotoxicity, genotoxicity and mutagenicity of novel biodegradable Zn-Mg alloys. Mater. Sci. Eng. C 2016, 58, 24–35. [Google Scholar] [CrossRef]
- Ma, J.; Zhao, N.; Zhu, D. Bioabsorbable zinc ion induced biphasic cellular responses in vascular smooth muscle cells. Sci. Rep. 2016, 6, 26661. [Google Scholar] [CrossRef]
- Dhamaniya, S.; Jacob, J. Synthesis and characterization of copolyesters based on tartaric acid derivatives. Polym. Bull. 2012, 68, 1287–1304. [Google Scholar] [CrossRef]
- Yang, Z.; Peng, H.; Wang, W.; Liu, T. Investigating the effect of PGA on physical and mechanical properties of electrospun PCL/PGA blend nanofibers. J. Appl. Polym. Sci. 2012, 124, 123–131. [Google Scholar]
- Jang, S.H.; Kim, D.H.; Park, D.H.; Kim, O.Y.; Hwang, S.H. Construction of sustainable polyurethane-based gel-coats containing poly(ε-caprolactone)-grafted lignin and their coating performance. Prog. Org. Coat. 2018, 120, 234–239. [Google Scholar] [CrossRef]
- Ahmadzadeh, Y.; Babaei, A.; Goudarzi, A. Assessment of localization and degradation of ZnO nano-particles in the PLA/PCL biocompatible blend through a comprehensive rheological characterization. Polym. Degrad. Stab. 2018, 158, 136–147. [Google Scholar] [CrossRef]
- Augustine, R.; Kalarikkal, N.; Thomas, S. Effect of zinc oxide nanoparticles on the in vitro degradation of electrospun polycaprolactone membranes in simulated body fluid. Int. J. Polym. Mater. Polym. Biomater. 2016, 65, 28–37. [Google Scholar] [CrossRef]
- Liuyun, J.; Yubao, L.; Chengdong, X. Preparation and biological properties of a novel composite scaffold of nano-hydroxyapatite/chitosan/carboxymethyl cellulose for bone tissue engineering. J. Biomed. Sci. 2009, 16, 1–10. [Google Scholar] [CrossRef] [Green Version]

| PCL/nHA Scaffold | PCL/nHA-ZnO10 Scaffold | PCL/nHA-ZnO100 Scaffold | PCL/nHA-ZnO200 Scaffold | |
|---|---|---|---|---|
| Target pore size | 500 μm | 500 μm | 500 μm | 500 μm |
| Target porosity | 50% | 50% | 50% | 50% |
| Sputtering time | - | 56 s | 562 s (9 min, 22 s) | 1125 s (18 min, 45 s) |
| Thickness of ZnO layer | - | 10 nm | 100 nm | 200 nm |
© 2020 by the authors. Licensee MDPI, Basel, Switzerland. This article is an open access article distributed under the terms and conditions of the Creative Commons Attribution (CC BY) license (http://creativecommons.org/licenses/by/4.0/).
Share and Cite
Cho, Y.S.; Kim, H.-K.; Ghim, M.-S.; Hong, M.W.; Kim, Y.Y.; Cho, Y.-S. Evaluation of the Antibacterial Activity and Cell Response for 3D-Printed Polycaprolactone/Nanohydroxyapatite Scaffold with Zinc Oxide Coating. Polymers 2020, 12, 2193. https://doi.org/10.3390/polym12102193
Cho YS, Kim H-K, Ghim M-S, Hong MW, Kim YY, Cho Y-S. Evaluation of the Antibacterial Activity and Cell Response for 3D-Printed Polycaprolactone/Nanohydroxyapatite Scaffold with Zinc Oxide Coating. Polymers. 2020; 12(10):2193. https://doi.org/10.3390/polym12102193
Chicago/Turabian StyleCho, Yong Sang, Hee-Kyeong Kim, Min-Soo Ghim, Myoung Wha Hong, Young Yul Kim, and Young-Sam Cho. 2020. "Evaluation of the Antibacterial Activity and Cell Response for 3D-Printed Polycaprolactone/Nanohydroxyapatite Scaffold with Zinc Oxide Coating" Polymers 12, no. 10: 2193. https://doi.org/10.3390/polym12102193






